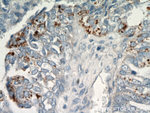
CHI3L1 Antibody in Immunohistochemistry (Paraffin) (IHC (P))

Search
Proteintech
CHI3L1 Polyclonal Antibody
{{$productOrderCtrl.translations['antibody.pdp.commerceCard.promotion.promotions']}}
{{$productOrderCtrl.translations['antibody.pdp.commerceCard.promotion.viewpromo']}}
{{$productOrderCtrl.translations['antibody.pdp.commerceCard.promotion.promocode']}}: {{promo.promoCode}} {{promo.promoTitle}} {{promo.promoDescription}}. {{$productOrderCtrl.translations['antibody.pdp.commerceCard.promotion.learnmore']}}
产品信息
12036-1-AP
种属反应
已发表种属
宿主/亚型
分类
类型
抗原
偶联物
形式
浓度
规格
纯化类型
保存液
内含物
保存条件
运输条件
产品详细信息
Immunogen sequence: YREGDGSCF PDALDRFLCT HIIYSFANIS NDHIDTWEWN DVTLYGMLNT LKNRNPNLKT LLSVGGWNFG SQRFSKIASN TQSRRTFIKS VPPFLRTHGF DGLDLAWLYP GRRDKQHFTT LIKEMKAEFI KEAQPGKKQL LLSAALSAGK VTIDSSYDIA KISQHLDFIS IMTYDFHGAW RGTTGHHSPL FRGQEDASPD RFSNTDYAVG YMLRLGAPAS KLVMGIPTFG RSFTLASSET GVGAPISGPG IPGRFTKEAG TLAYYEICDF LRGATVHRIL GQQVPYATKG NQWVGYDDQE SVKSKVQYLK DRQLAGAMVW ALDLDDFQGS FCGQDLRFPL TNAIKDALAA T (34-383 aa encoded by BC008568)
靶标信息
Human cartilage glycoprotein 39 (GP-39), also known as YKL-40, is a glycoprotein secreted by articular chondrocytes, synoviocytes and macrophages. Serum and synovial fluid GP-39 levels are elevated in inflammatory diseases and correlate with the degree of joint destruction in rheumatoid arthritis. GP-39 is expressed in articular chondrocytes and synovial cells, as well as in liver, but is undetectable in muscle tissues, lung, pancreas, mononuclear cells and fibroblasts. GP-39 is a candidate autoantigen in rheumatoid arthritis and is important in the capacity of cells to respond to and cope with changes in their environment.
仅用于科研。不用于诊断过程。未经明确授权不得转售。
生物信息学
蛋白别名: 39 kDa synovial protein; Breast regression protein 39; BRP39 protein; Cartilage glycoprotein 39; CGP-39; CGP39; Chitinase 3 like protein 1CGP 39; chitinase 3-like 1; chitinase 3-like 1 (cartilage glycoprotein-39); Chitinase-3-like protein 1; DKFZp686N19119; FLJ38139; GP-39; hCGP39; unnamed protein product; YKL-40
基因别名: ASRT7; AW208766; Brp39; CGP-39; CHI3L1; Chil1; GP-39; GP39; HC-gp39; hCGP-39; HCGP-3P; YK-40; YKL-40; YKL40; YYL-40
UniProt ID: (Human) P36222, (Mouse) Q61362
Entrez Gene ID: (Human) 1116, (Mouse) 12654